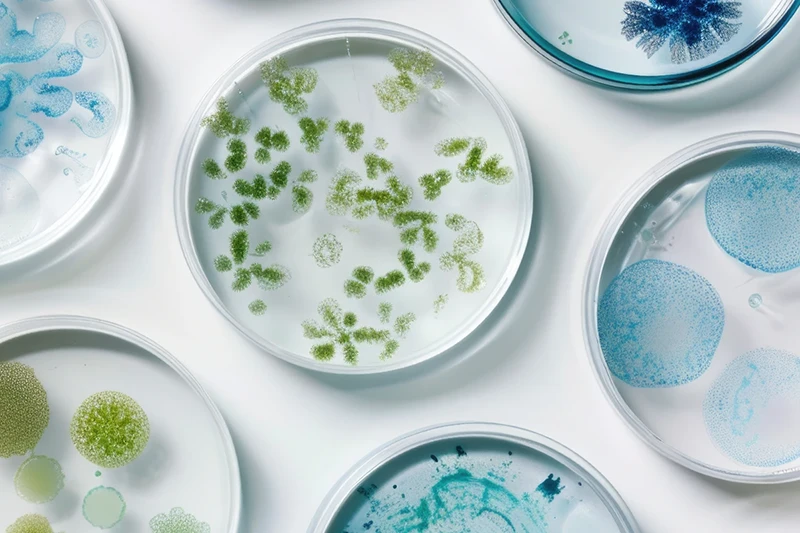
Depuratore Aria Casa per Inquinamento Domestico | ViruStop Air

Guida all'acquisto
Il miglior Purificatore d’Aria.
Come scegliere il purificatore d'aria migliore per le tue necessità
Scegliere il purificatore d’aria giusto per la propria casa o ufficio può migliorare significativamente la qualità dell’aria e il benessere generale.
Con numerosi modelli disponibili, ad esempio con i filtri al carbone attivo, è importante capire quali caratteristiche rispondono meglio alle tue esigenze. Fattori come la dimensione dell’ambiente, il tipo di agenti patogeni e inquinanti presenti e il budget possono influenzare la tua decisione.
Considerata la quantità di aspetti da tenere in considerazione nella scelta del miglior purificatore d’aria, abbiamo creato questa guida per orientarti tra i principali aspetti da considerare, aiutandoti nella ricerca di un purificatore capace di migliorare la qualità del tuo ambiente, sia per l’aria di casa che per l’ufficio.
Con numerosi modelli disponibili, ad esempio con i filtri al carbone attivo, è importante capire quali caratteristiche rispondono meglio alle tue esigenze. Fattori come la dimensione dell’ambiente, il tipo di agenti patogeni e inquinanti presenti e il budget possono influenzare la tua decisione.
Considerata la quantità di aspetti da tenere in considerazione nella scelta del miglior purificatore d’aria, abbiamo creato questa guida per orientarti tra i principali aspetti da considerare, aiutandoti nella ricerca di un purificatore capace di migliorare la qualità del tuo ambiente, sia per l’aria di casa che per l’ufficio.


Perchè e quando acquistare un purificatore d'aria
Un depuratore d’aria è un dispositivo che si adatta:
a tutte le tipologie persone: da chi ama l’aria pulita ogni giorno a chi ne ha bisogno per motivi di salute
a tutte le tipologie di ambienti: dalla casa, alle aziende, agli uffici fino alle scuole
Può essere un investimento fondamentale per migliorare la qualità dell’aria negli ambienti chiusi, specialmente per chi vive in una zona urbana con alti livelli di inquinamento.
Monitorare la qualità dell’aria in casa è importante e la sua depurazione è consigliata anche per chi soffre di allergie stagionali o di problemi respiratori, come l’asma. Inoltre, i purificatori possono essere utili per contrastare odori sgradevoli, fumi di sigaretta e la proliferazione di batteri o virus.
L’aria che respiriamo ha un impatto significativo sulla nostra salute, specialmente per i bambini, gli anziani e le persone con problemi particolari di salute.
a tutte le tipologie persone: da chi ama l’aria pulita ogni giorno a chi ne ha bisogno per motivi di salute
a tutte le tipologie di ambienti: dalla casa, alle aziende, agli uffici fino alle scuole
Può essere un investimento fondamentale per migliorare la qualità dell’aria negli ambienti chiusi, specialmente per chi vive in una zona urbana con alti livelli di inquinamento.
Monitorare la qualità dell’aria in casa è importante e la sua depurazione è consigliata anche per chi soffre di allergie stagionali o di problemi respiratori, come l’asma. Inoltre, i purificatori possono essere utili per contrastare odori sgradevoli, fumi di sigaretta e la proliferazione di batteri o virus.
L’aria che respiriamo ha un impatto significativo sulla nostra salute, specialmente per i bambini, gli anziani e le persone con problemi particolari di salute.
In quali ambienti posizionare il purificatore? Dalla casa all'ufficio
La funzionalità del depuratore d’aria lo rende adatto a tutti gli ambienti domestici e lavorativi.
A casa risulta particolarmente utile per le famiglie, soprattutto con bambini, anziani o persone con allergie, asma o altre condizioni respiratorie. Particolarmente vantaggioso anche per chi possiede animali domestici, grazie alla riduzione di allergeni come peli e forfora.
Gli ambienti di lavoro sono frequentati da molte persone contemporaneamente e richiedono, quindi, una maggiore attenzione. Negli uffici e negli spazi comuni, il purificatore contribuisce a creare un’atmosfera più salubre, riducendo la presenza di polveri, fumi e batteri, migliorando il benessere generale e la produttività.
A casa risulta particolarmente utile per le famiglie, soprattutto con bambini, anziani o persone con allergie, asma o altre condizioni respiratorie. Particolarmente vantaggioso anche per chi possiede animali domestici, grazie alla riduzione di allergeni come peli e forfora.
Gli ambienti di lavoro sono frequentati da molte persone contemporaneamente e richiedono, quindi, una maggiore attenzione. Negli uffici e negli spazi comuni, il purificatore contribuisce a creare un’atmosfera più salubre, riducendo la presenza di polveri, fumi e batteri, migliorando il benessere generale e la produttività.
La tecnologia ViruStop Air risulta inoltre particolarmente efficace nell’eliminazione di virus e batteri: per questo il suo utilizzo è indicato negli ambienti scolastici, dove questi microrganismi si accumulano facilmente, favorendo la rapida diffusione di infezioni tra i bambini, che spesso si trasmettono malattie a vicenda.
Dove è più indicato posizionare il purificatore? Per ottenere i migliori risultati, è essenziale mettere il purificatore d’aria negli ambienti più frequentati, come il soggiorno o la camera da letto. In casa, puoi collocarlo anche vicino a fonti di inquinanti, come la cucina o le stanze dove si accumulano più fumi e polvere. In ufficio, è ideale sistemarlo negli spazi condivisi o in prossimità delle scrivanie.
Assicurati che il purificatore sia posizionato in una zona centrale e aperta per garantire una distribuzione uniforme dell’aria pulita. È anche importante considerare le dimensioni in metri quadrati dell’ambiente, per scegliere un dispositivo con la giusta portata d’aria.
Dove è più indicato posizionare il purificatore? Per ottenere i migliori risultati, è essenziale mettere il purificatore d’aria negli ambienti più frequentati, come il soggiorno o la camera da letto. In casa, puoi collocarlo anche vicino a fonti di inquinanti, come la cucina o le stanze dove si accumulano più fumi e polvere. In ufficio, è ideale sistemarlo negli spazi condivisi o in prossimità delle scrivanie.
Assicurati che il purificatore sia posizionato in una zona centrale e aperta per garantire una distribuzione uniforme dell’aria pulita. È anche importante considerare le dimensioni in metri quadrati dell’ambiente, per scegliere un dispositivo con la giusta portata d’aria.
Benefici e vantaggi dei migliori purificatori d'aria
I purificatori d’aria migliori offrono una serie di benefici che migliorano notevolmente la qualità dell’aria e il comfort all’interno degli ambienti chiusi. Grazie a tecnologie e filtri avanzati, come il filtro a carbone attivo, possono eliminare una vasta gamma di inquinanti, dalle particelle di polvere ai gas nocivi.
I principali vantaggi di respirare aria pulita grazie al purificatore:
I principali vantaggi di respirare aria pulita grazie al purificatore:
Virus e batteri
Polline e polvere
Fumi
Muffa
Famiglia e bambini
Animali domestici

Virus e batteri
Negli ambienti condivisi, come uffici o scuole, i virus e i batteri si diffondono facilmente. I purificatori d’aria migliori e avanzati, dotati di tecnologie come i raggi UV-C implementate grazie ai filtri ai raggi ultravioletti, possono neutralizzare virus e batteri, riducendo il rischio di infezioni. Questo tipo di purificatori è particolarmente indicato per chi vuole mantenere un ambiente sano e sicuro, soprattutto durante le stagioni influenzali.

Allergie: pollini e polvere
Per chi soffre di allergie stagionali, per esempio ai pollini, e allergie causate da allergeni domestici, come acari della polvere e peli di animali, i purificatori con filtri a carbone attivo sono una scelta eccellente. Questi filtri possono catturare fino al 97% delle particelle in sospensione, migliorando significativamente la qualità dell’aria e riducendo i sintomi allergici in casa e ufficio.

Fumi
Se vivi in zone soggette a incendi o in prossimità di attività industriali, i purificatori d’aria possono proteggerti dal fumo, gli odori e i gas tossici. I modelli con filtri a carbone attivo sono ideali per rimuovere le particelle pericolose e neutralizzare gli odori, rendendo l’aria più respirabile. Questa capacità è particolarmente utile anche per chi cerca di eliminare fumo di sigaretta negli spazi chiusi e odori della cucina.
Muffa
In ambienti umidi come bagni e scantinati, la muffa può rappresentare un grave rischio per la salute, soprattutto per chi soffre di allergie o problemi respiratori. I purificatori d’aria con filtri di qualità e altre tecnologie di purificazione, come la luce UV-C, possono catturare e distruggere le spore di muffa presenti nell’aria, prevenendo la loro proliferazione e migliorando la qualità complessiva dell’aria.

Famiglia e bambini
I purificatori d’aria offrono un notevole vantaggio per la salute della famiglia, in particolare per i bambini e i neonati, i cui sistemi immunitari sono ancora in fase di sviluppo. Garantire un’aria pulita priva di inquinanti, allergeni e fumi contribuisce a creare un ambiente più sicuro e salutare per i piccoli, proteggendoli dagli effetti negativi dell’inquinamento domestico.

Animali domestici
Un purificatore d’aria può essere un alleato prezioso per ridurre la forfora e i peli di animali domestici che possono causare allergie. I filtri a carbone attivo e i filtri a raggi UV sono particolarmente efficaci nel catturare queste particelle, migliorando la qualità dell’aria per chi vive con animali e garantendo un ambiente più salubre sia per i proprietari che per gli ospiti sensibili agli allergeni animali.
Scegliere il purificatore con tecnologie innovative e sostenibili
Nella scelta del miglior purificatore d’aria professionale, è importante considerare non solo l’efficacia nella purificazione, ma anche l’adozione di tecnologie innovative e sostenibili. I purificatori più avanzati utilizzano filtri riutilizzabili, riciclabili o a lunga durata riducendo l’impatto ambientale.
Alcuni modelli integrano sensori intelligenti per monitorare in tempo reale la qualità dell’aria, regolando automaticamente la potenza in base ai livelli di inquinamento rilevati. Inoltre, i dispositivi dotati di tecnologie di purificazione a basso consumo energetico garantiscono un minor impatto sull’ambiente, rendendo la scelta più sostenibile e responsabile.
Alcuni modelli integrano sensori intelligenti per monitorare in tempo reale la qualità dell’aria, regolando automaticamente la potenza in base ai livelli di inquinamento rilevati. Inoltre, i dispositivi dotati di tecnologie di purificazione a basso consumo energetico garantiscono un minor impatto sull’ambiente, rendendo la scelta più sostenibile e responsabile.

10 Caratteristiche del miglior purificatore d'aria
Nella selezione dei migliori purificatori d’aria sono comprese svariate peculiarità, tra le più significative:
- Versatilità in ogni ambiente: si adattano perfettamente sia a spazi domestici che professionali, garantendo una purificazione ottimale dell’aria in ambienti di diverse dimensioni.
- Prodotto 100% made in Italy: l’acquisto di purificatori progettati e realizzati in Italia, oltre a contribuire positivamente sull’economia delle aziende italiane, garantisce un alto livello di qualità e performance superiori.
- Tecnologia antibatterica e antivirale: alcuni modelli avanzati integrano trattamenti UV o ionizzatori in grado di purificare l’aria neutralizzando i virus e i batteri presenti, migliorando l’igiene complessiva. L’utilizzo di filtri ai raggi ultravioletti consente di disattivare i virus presenti nell’aria.
- Funzionalità ad ampio spettro: questi dispositivi sono in grado di eliminare una vasta gamma di inquinanti, come polveri sottili, pollini, allergeni e gas nocivi.
- Design compatto e portatile: i modelli leggeri e compatti, possono essere facilmente spostati e collocati in diverse stanze, dalla camera da letto all’ufficio a seconda delle esigenze.
- Funzionamento silenzioso: i purificatori progettati per funzionare in modo discreto, sono ideali anche per l’uso notturno in camere da letto o in uffici, garantendo un ambiente tranquillo e privo di rumori fastidiosi.
- Basso consumo energetico: i dispositivi più moderni sono progettati per essere efficienti dal punto di vista energetico, riducendo l’impatto ambientale e i costi della bolletta elettrica.
- Facilità di manutenzione: se dotati di filtri facilmente lavabili o sostituibili, i purificatori d’aria richiedono poca manutenzione e garantiscono una lunga durata.
- Filtro a carbone attivo: efficace nell’eliminazione di odori persistenti e gas nocivi come i composti organici volatili, garantendo un’aria più fresca.
- Filtro a Raggi UV di alta qualità: consente di catturare fino al 99,97% delle particelle microscopiche, come polveri sottili, pollini e allergeni, migliorando la qualità dell’aria.
- Ottimo rapporto qualità-prezzo: i dispositivi che offrono un’eccellente combinazione di prestazioni elevate e costi accessibili, risultano una soluzione economica e performante per migliorare la qualità dell’aria.


Perchè scegliere un purificatore d'aria ViruStop Air?
L’acquisto di un purificatore d’aria è sempre una buona idea. Soprattutto se si tratta di un prodotto 100% Made in Italy nato dalla passione e dalla ricerca, realizzato con tecnologie all’avanguardia e testato in ambienti medici e ambulatoriali.
Il nostro purificatore è la soluzione ideale in quanto combina efficienza, neutralizzando agenti patogeni e inquinanti, design colorato e personalizzabile, discrezione, con un funzionamento silenzioso, e sistema di filtraggio sostenibile, grazie ai materiali riciclabili. Se sei alla ricerca di un dispositivo adatto ad ogni ambiente e metratura, ViruStop Air è la risposta versatile.
Il nostro purificatore è la soluzione ideale in quanto combina efficienza, neutralizzando agenti patogeni e inquinanti, design colorato e personalizzabile, discrezione, con un funzionamento silenzioso, e sistema di filtraggio sostenibile, grazie ai materiali riciclabili. Se sei alla ricerca di un dispositivo adatto ad ogni ambiente e metratura, ViruStop Air è la risposta versatile.
Scopri il purificatore ViruStop Air
Ora hai a disposizione tutte le informazioni che servono per poter scegliere il miglior purificatore d’aria adatto alle tue esigenze, a quelle della tua famiglia o dei tuoi colleghi e dipendenti!

